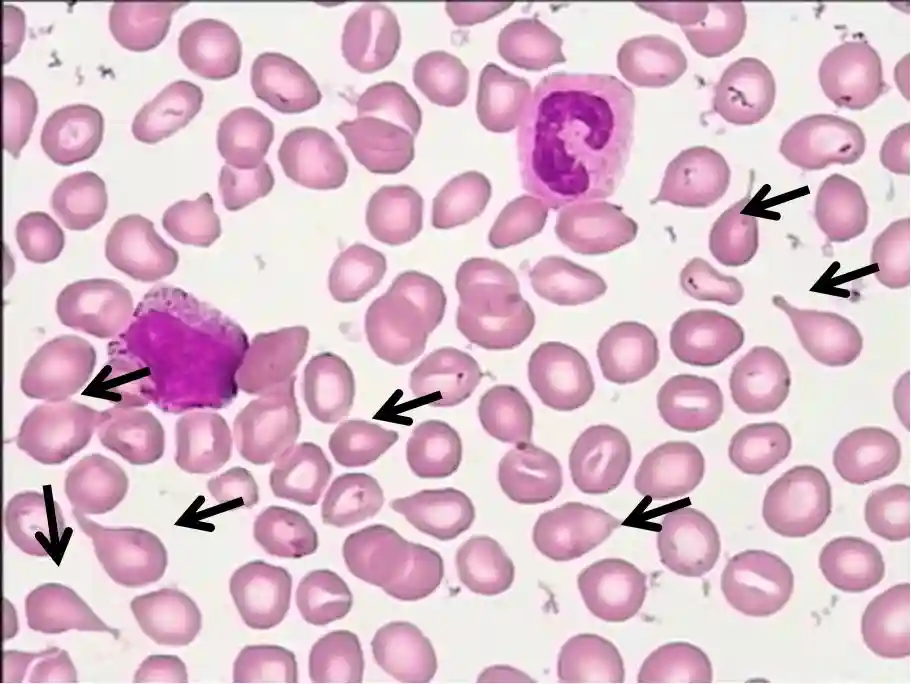
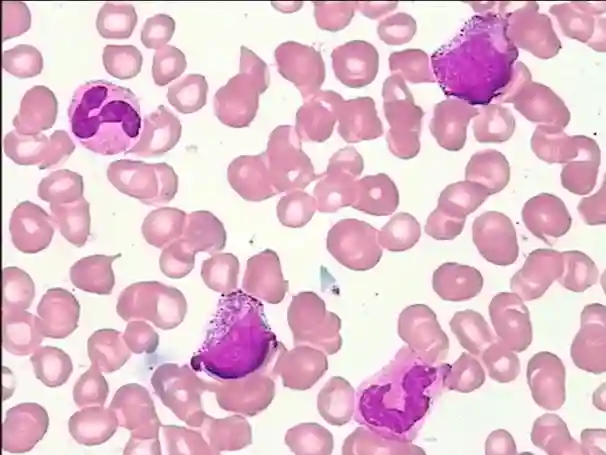
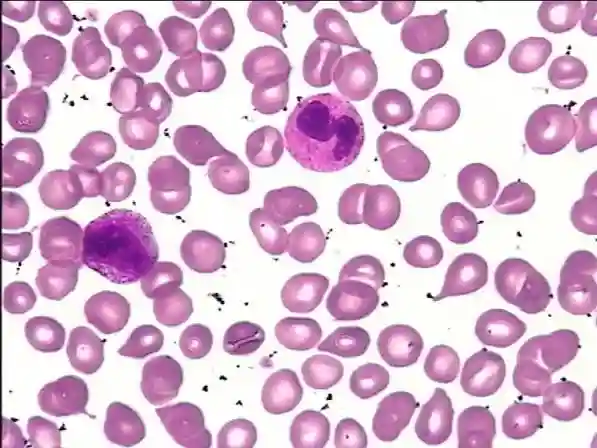

前言

本例患者因“诊断原发性肝癌、原发性胆汁性肝硬化-失代偿期、多发性骨转移”,1年来从基层辗转各地治疗未见好转,遂来肿瘤科就诊,入院血常规白细胞轻度减低,外周血涂片见原始粒细胞占2%,中晚幼粒细胞占30%,并见有核红细胞,成熟红细胞大小不等,泪滴红细胞易见,怀疑为骨髓增殖性肿瘤,进一步行骨髓细胞学、骨髓病理及基因检测,最终明确诊断为原发性骨髓纤维化,并纠正诊断为“原发性骨髓纤维化”。通过外周血细胞形态学分级报告发现蛛丝马迹,对较为隐匿的原发性骨髓纤维化给与提示,帮助临床明确诊断方向,为患者提供及时、准确的诊治。
案例经过
患者女性,55岁,因“原发性肝癌、多发性骨转移”于2019年6月25日就诊于我院肿瘤科。住院期间实验室检查,白细胞3.49×109/L,血红蛋白114g/L,血小板172×109/L;血细胞形态:原始粒细胞占2%,中晚幼粒细胞占30%,杆状核粒细胞比例增高占16%,部分粒细胞可见中毒颗粒,异淋占5%。成熟红细胞大小不等,易见泪滴红细胞(6%/3+),计数100个有核细胞可见2个晚幼红细胞。
血小板散在、成簇可见;血清生化:胆固醇7.99mmol/L,低密度脂蛋白胆固醇4.55mmol/L,葡萄糖3.87mmol/L,微量元素锌6.5umol/L,铜30.8umol/L;肝功:/L↑,γ-GGT150U/L↑,/L↑,μmol/L↑,μmol/L↑,μmol/L↑;抗线粒体抗体M2:41.0U/mL;外科综合、便常规、尿常规、凝血常规及免疫五项等未见异常。
心电:窦性心律,正常心电。初次诊断原发性肝癌、原发性胆汁性肝硬化失代偿期、胆囊炎、胆囊结石、支气管炎、肺炎、骨转移癌、肺部多发结节等。后经多学科会诊,依据患者住院期间外周血出现白细胞减低,外周血涂片检查发现幼稚粒红细胞,怀疑有髓外造血,进一步根据骨髓细胞学、骨髓病理、肝脏穿刺活检病理、染色体核型等检查结果更正临床诊断为原发性骨髓纤维化、肝占位性病变(髓外造血)、多发骨质改变、双肺多发结节(髓外造血)、双侧腹股沟淋巴结肿大(髓外造血)、脾脏肿大(髓外造血)、原发性胆汁性胆管炎。
临床案例分析
该患者1年前出现持续腹胀、巩膜黄染伴双下肢水肿,当地诊断为“原发性肝癌、多发性骨转移”,1年来从基层辗转各地治疗未见好转。患者入院后,经影像科、超声科、肝胆外科、介入科、放疗科多学科会诊认为不适合外科手术,建议在肿瘤科治疗。入院时存在以下临床情况:
腹胀、乏力及肝功能改变。患者1年来持续腹胀、乏力,肝功/L↑,γ-GGT150U/L↑,/L↑,μmol/L↑,μmol/L↑,μmol/L↑;抗线粒体抗体M2:41.0U/mL↑。
可明确诊断为原发性胆汁性胆管炎(PBC)。PBC累及肝内小胆管引发淤积性胆管炎出现腹胀、乏力和黄疸,此外,作为一种自身免疫性疾病,还可引起血细胞减少。
肝脏、肺部、腹股沟、脾脏多发占位及外周血形态学改变。①入院提示:患者多发占位起初考虑为转移灶,而外周血涂片发现泪滴红细胞6%(3+),分类100个有核细胞见有核红细胞2个,原始粒细胞占2%(2+),中晚幼粒细胞占30%(3+)。
②检验提示髓外造血可能,不除外骨髓增殖性肿瘤或其他血液系统疾病,进一步行骨髓细胞学、骨髓病理、细胞遗传学或分子生物学(JAK2-V617F,CALR,MPL等)等检测后,诊断为原发性骨髓纤维化(PMF)。
③病理提示及纠正诊断:进一步行肝脏穿刺活检提示造血细胞增生,将多发占位纠正诊断为髓外造血。
PMF是一种造血干细胞克隆性增殖导致的骨髓增殖性肿瘤(MPN),以骨髓衰竭和髓外造血为特点。该病症状隐匿常不典型,有时乏力、腹胀,血常规三系减少,表现为不同程度的血细胞减少和/细胞增多、外周血出现幼红、幼粒细胞、骨髓纤维化和髓外造血等。
由于各系造血细胞严重受损及重度肿大脾脏的扣留,约10%的患者表现为全血细胞减少[3]。PMF按疾病进展分为纤维化前期和纤维化明显期。PMF可由其他类型MPN转化而来,晚期骨髓衰竭,少数转化为急性白血病,因此后续对患者持续密切监测。
患者明确诊断PMF后,给予口服芦可替尼规律治疗,并监测血常规及血细胞形态,患者自此摆脱“癌症晚期”阴云。
检验案例分析
该患者以腹胀、乏力为主症,因“诊断原发性肝癌、原发性胆汁性肝硬化-失代偿期、多发性骨转移”而就诊。实验室指标的主要变化有:①白细胞减低,外周血涂片(图1)发现原始粒细胞占2%,中晚幼粒细胞占30%,杆状核粒细胞比例增高占16%,成熟红细胞大小不等,泪滴红细胞易见(6%/3+),分类100个有核细胞见有核红细胞2个;②/L↑,γ-GGT150U/L↑,/L↑,μmol/L↑,μmol/L↑,μmol/L↑;③抗线粒体抗体M2:41.0U/mL↑。
图1外周血细胞形态(瑞氏-吉姆萨染色,×40)
血细胞数量及形态变化的分析:根据《血细胞分析报告规范化指南》[1],外周血细胞形态报告建议分为3个层次:①层次1——对观察到的异常形态进行简明规范的综合描述,避免使用模糊术语;②层次2——视情况提出可能的诊断或排除诊新的建议;③层次3——在层次1和层次2的基础上,视情况提出下一步需进行的检查或采取的措施。
在层次1中,对于异常血细胞的形态报告采用分级报告模式,分级报告可采用双层报告,即程度和(或)百分比,程度包含“1+(轻度)”“2+(中度)”和3+(重度)”3个等级。通常在异常血细胞形态达“2+”和“3+”时给予报告。对于百分比的报告方法,按照《ICSH外周血细胞形态特征的命名和分级标准化建议》[2],对大多数红细胞异常形态,应至少评估1000个红细胞中形态异常红细胞的百分比,并注意排除推片等因素的影响。
由上,该患者外周血细胞异常形态分级报告如下:
层次1——泪滴红细胞6%(3+),分类100个有核细胞见有核红细胞2个,原始粒细胞占2%(2+),中晚幼粒细胞占30%(3+)。
层次2——考虑骨髓增殖性肿瘤、髓外造血血液系统疾病。
层次3——建议进一步结合骨髓细胞学、骨髓病理、细胞遗传学或分子生物学,并完善JAK2V617F、CALR等基因突变检测。
检验科向临床提示上述情况,进一步行骨髓涂片、病理检查、染色体及基因突变检测。骨髓细胞学显示骨髓取材干抽增生尚活跃,红系比例减低,巨核细胞少,淋巴细胞比例减低;外周血易见幼稚粒细胞、幼稚红细胞及泪滴红细胞;血小板成堆易见(图2-3)。
图2骨髓涂片(吉姆萨染色,×40)
图3末梢血涂片(吉姆萨染色,×40)
骨髓病理(图4-5)显示HE及PAS染色示送检组织骨质增多,大量新骨形成,相互连接成网状结构,骨髓空间全面消失。网状纤维染色(MF-3级)。

图4骨髓活检(HE染色,×10)

图5骨髓活检(HE染色,×40)
诊断意见:骨髓纤维化,需结合临床及基因学等检查。染色体检查(图6):46,XX,del(13)(q1222)[4]/46,XX[7]。基因检测:CALRTypel阳性,BCR/ABL融合基因、JAK2-V617F、MPL-W515L/K阴性。诊断为原发性骨髓纤维化。

图6染色体核型检查
患者肝穿病理(图7)报告造血细胞增生,考虑髓外造血。纠正诊断为原发性骨髓纤维化,肝脾肿大、肝脏、肺部、腹股沟、脾脏多发占位系髓外造血所致。

图7肝脏活检穿刺活检病理(HE染色,×40)
本病例检验与临床沟通在第一时间沟通,利用外周血细胞异常形态分级报告,即将外周血涂片形态学检查发现的泪滴红细胞和原始幼稚粒细胞报告给临床,并将可能的诊断、进一步需要检查的项目建议给临床,为临床医生提供诊疗线索,为疑难病例的诊断提供了方向。
知识拓展
原发性骨髓纤维化(PMF)是由异常造血干细胞克隆性增殖,导致进行性骨髓纤维化的一种骨髓增殖性肿瘤(MPN)。最为常见的临床表现为严重乏力,发生率为50%~70%;通常脾肿大较为显著,患者可能诉左上腹不适、早饱,有时会有左肩痛;大部分患者可触及肝肿大,门静脉高压可能由脾肿大引起的内脏血流量增加或髓外造血相关的肝内堵塞导致;同时会发生骨及关节受累,可能发生动静脉血栓,且几乎所有器官都可能出现髓外造血灶[4]。
本病早期为增殖期,或称为骨髓纤维化前期,骨髓显著增生,伴或不伴少量网硬蛋白纤维;后期则为骨髓纤维化明显期,骨髓中造血细胞明显减少,伴大量网硬蛋白纤维或胶原纤维增生为主,常有骨髓硬化,本期突出特点是外周血中出现幼红、幼粒细胞及泪滴形红细胞。
实验室检查血象显示,患者常有轻或中度贫血,为正细胞正色素性。白细胞轻到中度增高,大多在(10~30)×109/L,以成熟中性粒细胞为主,可有核左移,偶见原始细胞,部分也可出现白细胞减少。血小板可显著增高,由于血细胞增生难与其他MPN鉴别;在骨髓衰竭期也可以减少。骨髓象示疾病早期骨髓造血细胞仍可增生,特别是粒系和巨核细胞。
但后期显示增生低下,因骨髓纤维化骨髓穿刺常干抽,示有核细胞增生大多减低,与外周血涂片接近。骨髓活检在纤维化前期,骨髓主要以粒系和巨核细胞增生为主,并且不典型巨核细胞,经常密集成簇分布。;在纤维化明显期,网硬蛋白纤维和胶原蛋白纤维增生,造血细胞减少,骨髓造血逐步呈衰竭状态,最后出现骨髓硬化;基因突变检查约80%-90%的患者有JAK2V617F、CARL及MPL基因突变;血小板功能缺陷致出血时间延长,血小板黏附性及聚集性降低。
2016版WHO[4]提出对PMF明显期的诊断需要同时符合以下三个主要标准和至少一个次要标准:
(1)主要标准:
a.有巨核细胞增生和异形巨核细胞,常伴有网状纤维和胶原纤维增多(MF-2或MF-3)
b.不能满足真性红细胞增多症、慢性粒细胞白血病(BCR-ABL融合基因阴性)、骨髓增生异常综合征(无粒系和红系病态造血)或其他髓系肿物的WHO诊断标准
c.有JAK2、CALR或MPL突变或无这些突变但有其他克隆性标志,或无反应性骨髓纤维化的证据。
(2)次要标准:
a.非合并疾病导致的贫血
≥11×109/L
c.可触及的脾大
d.血清乳酸脱氢酶(LDH)增高
e.幼粒幼红血象。
PMF的实验室检测方法,除WHO提到的项目外,通过半固体集落培养法发现患者血液中多潜能、粒系、单核系、红系和巨核系祖细胞浓度增高[3]。
血液中造血祖细胞浓度与骨髓网状纤维密度相关,血CD34+细胞数升高是原发性骨髓纤维化非常特征性的表现,,且CD34+细胞数升高的程度与疾病的严重程度以及疾病的进展相关。血CD34+细胞数大于15x106/L则基本可诊断为原发性骨髓纤维化,CD34+细胞数大于300x106/L的患者比CD34+细胞数较少的患者疾病进展更快。
原发性骨髓纤维化患者血中的内皮细胞祖细胞(CD133和VEGFR2+细胞)较正常人明显升高。由于CD3/CD4/CD8和CD3/CD56T细胞数量的减少,导致淋巴细胞轻度减少。
案例总结
PMF是一种造血干细胞克隆性增殖导致的骨髓增殖性肿瘤(MPN),以骨髓衰竭和髓外造血为特点。该病症状隐匿常不典型,表现为不同程度的血细胞减少和/细胞增多、外周血出现幼红、幼粒细胞、骨髓纤维化和髓外造血等。本例患者因“肝癌及多发转移”辗转于多个医院就诊,所幸在血涂片中发现异常血细胞,临床根据检验提供的线索,经骨髓涂片、骨髓活检、基因检测等诊断出原发性骨髓纤维化,经肝脏穿刺活检证实诊断为髓外造血,排除肝癌及多发转移(图8)。检验对异常外周血形态的分层报告为临床提供清晰的诊断思路,体现出血细胞形态学镜检分层报告的必要性,以及临床沟通的重要性。

图8患者诊断过程
专家点评
吉林大学第一医院检验科曲林琳教授
PMF以骨髓衰竭和髓外造血为特点,从其诊断标准中可以看出,PMF的诊断以实验室检查为主,并在排除真性红细胞增多症、慢性髓系白血病及骨髓增生异常综合征或其他髓系肿瘤之后。由于PMF患者外周血出现不同程度增高的泪滴形红细胞、有核红细胞、原始幼稚粒细胞,检验科在日常工作中认真严谨的镜检十分重要;另一方面,对这些异常形态进行分析,利用分层报告的方式,将异常形态、可疑的疾病及进一步检查建议提供给临床医生,给临床诊疗提示清晰的思路和方向,从而明确诊断、纠正临床诊断,为患者洗脱“癌症晚期”的困扰,减轻其身心负担,彰显出检验工作者扎实的基础理论、丰富的检验医学经验和高度负责的工作态度。检验科工作与疾病诊断密切相关,检验人员应不断跟进检验相关共识、指南,了解相关临床医学知识,注重在工作中不断总结和积累,积极与临床沟通,协助医生共同为患者做好诊疗服务。
参考文献
[1]崔巍,续薇.血细胞分析报告规范化指南[J].中华检验医学杂志,2020,43(06):619-627.
[2]Palmer,Briggs,McFadden,gofperipheralbloodcellmorphologicalfeatures[U].intJLabHematol,2015;37(3):287-303.
[3]KaushanskyLichtmanBeutler,KippsSeligsohnPrchal,陈竺译.《威廉姆斯血液病学》.北京:人民卫生出版社,2010.
[4]段瑞.WHO造血与淋巴组织肿瘤分类(2016)[J].诊断病理学杂志,2017,24(12):956-958.
声明:本平台旨在为医疗卫生专业人士传递更多医学信息。本平台发布的内容,不能以任何方式取代专业的医疗指导,也不应被视为诊疗建议。如该等信息被用于了解医学信息以外的目的,本平台不承担相关责任。本平台对发布的内容,并不代表同意其描述和观点。若涉及版权问题,烦请权利人与我们联系,我们将尽快处理。